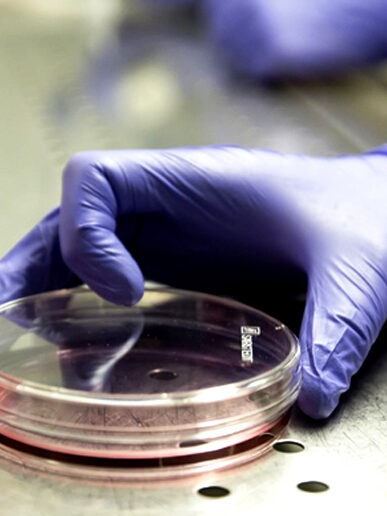

With Ufficio Brevetti, managed by Studio CELSUS, a series of innovative and quality online services are born for inventors and companies, carried out by professionals who are experts in various technical and legal disciplines.
Europa creativa
La vetrina multimediale più visitata in rete. Un infinità di idee per investitori e aziende.
MoreOur services
Last news
Telephone numbers
+39 0587 734105
+39 349 7420601
+39 349 7420601
Address
Ufficio Brevetti
by Studio Celsus Ponsacco (Pisa)
by Studio Celsus Ponsacco (Pisa)
info@ufficio-brevetti.it